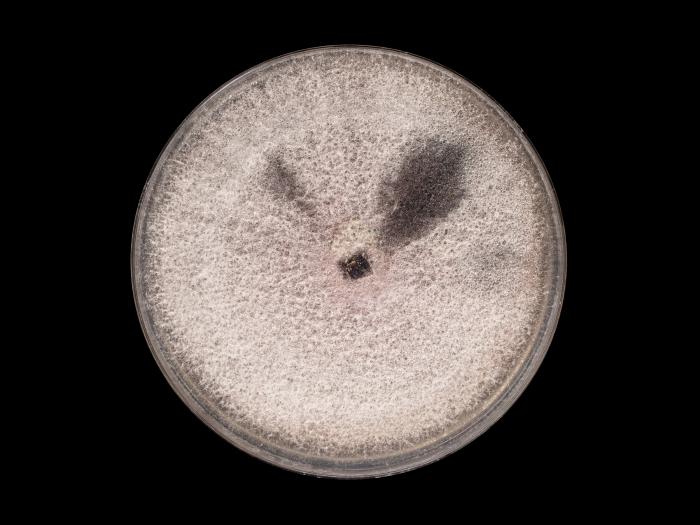
Fusarium_oxysporum_12

- Culture : Aucun pigment coloré ou pigment violet (pâle ou foncé) apparaissant dans le milieu de culture PDA (visible dessous).
- Mycélium : Septé.
- Macroconidies : Phragmospores à 3-5 septations transversales (mais généralement 3 septations). Droites ou légèrement falciformes (= en forme de faucille très discrète). À parois minces. Cellule apicale sans caractéristique spéciale. Cellule basale en forme de pied ou pointue. Pouvant être regroupées en sporodochies crème à saumon. Dimension : 27-46 × 3-5 μm (si 3 septations), 35-60 × 3-5 μm (si 5 septations) et 50-66 × 3,5-5 μm (si 6-7 septations).
- Microconidies : 0 septation (= amérospores) (habituellement) / 1 septation (= didymospores) (rarement). Agglomérées en "fausses têtes". Hyalines. De forme variable (ovale/ellipsoïde à cylindrique). Droites ou incurvées. Dimension : 5-12 x 2,2-3,5 μm. Produites par de courtes monophialides (absence de polyphialide) qui sont localisées latéralement sur l'hyphe ou sur de courts conidiophores faiblement ramifiés.
- Chlamydospores : Seules ou en chaînes de deux. Intercalaires ou terminales. Uniformes et globuleuses. Paroi épaisse et lisse. Formées à partir des hyphes ou des macroconidies.
Distinction entre Fusarium oxysporum et Fusarium subglutinans :
- F. oxysporum : Microconidies portées par des monophialides + Production de chlamydospores.
- F. subglutinans : Microconidies portées par des polyphialides + Aucune chlamydospore.
Distinction entre Fusarium oxysporum, Fusarium solani et Fusarium verticillioides :
- F. oxysporum : Courtes monophialides (portant les microconidies) + Microconidies agglomérées en "fausses têtes".
- F. solani : Longues monophialides (portant les microconidies) + Microconidies agglomérées en "fausses têtes".
- F. verticillioides : Longues monophialides (portant les microconidies) + Microconidies agglomérées en "fausses têtes" ou produites en chaînes.
Ce champignon est reconnu pour affecter le système vasculaire de plusieurs cultures et il cause un flétrissement des parties aériennes. Cette maladie est souvent nommée le flétrissement fusarien.
Le champignon Fusarium oxysporum peut affecter les cultures suivantes : ail, armoise, asperge, aubergine, balsamine des jardins, betterave potagère, betterave sucrière, bette-à-carde, bleuet en corymbe, bleuet nain, canola/colza, céleri, cerisier, chou pommé, chou-fleur, chou de bruxelles, chrysanthèmes, ciboulette, citrouille, clarkie, concombre, cyclamens, delphinium, dracénas, échinacées, épinard, épinettes, fèves, freesia, frênes, ginseng d'amérique, glaïeuls, godéties, gourgane, haricots vert et jaune, immortelles, laitues, lavatères, lentille, lin, lis, lupins, luzerne, maïs grain et fourrager, maïs sucré, mélèzes, melon d'eau, melons (cantaloup, melon miel, etc.), narcisse, nigelle, noyers, œillets, oignon sec, oignon vert, ormes, pins, poireau, pois chiche, pois de senteur, pois vert, pois sec, poivron, pomme, pomme de terre, radis oriental, reine-marguerite, sapins, sauges, soya, tabac, tagètes, tomate, trèfle, tulipes et véroniques.
Booth C. (1971). The Genus Fusarium. Commonwealth Mycological Institute, Kew, Surrey, England. 237 p.
International Mycological Institute (IMI). Descriptions of Fungi and Bacteria. CAB International (CABI), Kew, Surrey, United Kingdom.
Leslie J.F. & Summerell B.A. (2006). The Fusarium Laboratory Manual. Blackwell Publishing. 388 p.
Nelson P.E., Toussoun T.A. & Marasas W.F.O. (1983). FUSARIUM SPECIES: An Illustrated Manuel for Identification. The Pennsylvania State University Press. 193 p.
Noms des maladies des plantes au Canada - 4e édition (2003). Société de protection des plantes du Québec (SPPQ). 340 p.
Mycobank : Taxa descriptions (Fusarium oxysporum)
Cultures ou autres organismes affectés
Ail
 Ail - Pourriture fusarienne (Fusarium oxysporum)_2
Ail - Pourriture fusarienne (Fusarium oxysporum)_2
 Ail - Pourriture fusarienne (Fusarium oxysporum)_3
Ail - Pourriture fusarienne (Fusarium oxysporum)_3
 Ail - Pourriture fusarienne (Fusarium oxysporum)_4
Ail - Pourriture fusarienne (Fusarium oxysporum)_4

Céleri
 Céleri - Fusariose vasculaire (Fusarium oxysporum)_2
Céleri - Fusariose vasculaire (Fusarium oxysporum)_2
 Céleri - Fusariose vasculaire (Fusarium oxysporum)_3
Céleri - Fusariose vasculaire (Fusarium oxysporum)_3
 Céleri - Fusariose vasculaire (Fusarium oxysporum)_4
Céleri - Fusariose vasculaire (Fusarium oxysporum)_4
 Céleri - Fusariose vasculaire (Fusarium oxysporum)_5
Céleri - Fusariose vasculaire (Fusarium oxysporum)_5

Chou pommé

Concombre
 Concombre - Fusariose vasculaire (Fusarium oxysporum)_2
Concombre - Fusariose vasculaire (Fusarium oxysporum)_2
 Concombre - Fusariose vasculaire (Fusarium oxysporum)_3
Concombre - Fusariose vasculaire (Fusarium oxysporum)_3
 Concombre - Fusariose vasculaire (Fusarium oxysporum)_4
Concombre - Fusariose vasculaire (Fusarium oxysporum)_4

Cordylines
Cyclamens

Dracénas
 Dracénas - Pourriture fusarienne (Fusarium oxysporum)_2
Dracénas - Pourriture fusarienne (Fusarium oxysporum)_2
 Dracénas - Pourriture fusarienne (Fusarium oxysporum)_3
Dracénas - Pourriture fusarienne (Fusarium oxysporum)_3
 Dracénas - Pourriture fusarienne (Fusarium oxysporum)_4
Dracénas - Pourriture fusarienne (Fusarium oxysporum)_4
 Dracénas - Pourriture fusarienne (Fusarium oxysporum)_5
Dracénas - Pourriture fusarienne (Fusarium oxysporum)_5

Gourgane
 Gourgane - Pourriture fusarienne (Fusarium oxysporum)_2
Gourgane - Pourriture fusarienne (Fusarium oxysporum)_2

Haricot
 Haricot - Fusariose vasculaire (Fusarium oxysporum)_2
Haricot - Fusariose vasculaire (Fusarium oxysporum)_2

Maïs grain et fourrager
 Maïs grain et fourrager - Piétin fusarien (Fusarium oxysporum)_2
Maïs grain et fourrager - Piétin fusarien (Fusarium oxysporum)_2
 Maïs grain et fourrager - Piétin fusarien (Fusarium oxysporum)_3
Maïs grain et fourrager - Piétin fusarien (Fusarium oxysporum)_3
 Maïs grain et fourrager - Piétin fusarien (Fusarium oxysporum)_4
Maïs grain et fourrager - Piétin fusarien (Fusarium oxysporum)_4
 Maïs grain et fourrager - Piétin fusarien (Fusarium oxysporum)_5
Maïs grain et fourrager - Piétin fusarien (Fusarium oxysporum)_5